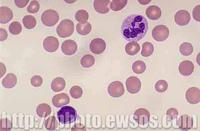
小細胞低色素貧血

簡介
在缺鐵性貧血的早期,多為正常細胞性貧血,表現為輕度貧血;隨著進展,紅細胞和血紅蛋白進一步下降,出現明顯的小細胞低色素性貧血,呈典型的缺鐵性貧血。所以出現典型小細胞低色素貧血,可見於缺鐵性貧血的晚期。
分類別
貧血按紅細胞的形態學進行分類,通常可分為:大細胞性貧血、正常細胞性貧血、單純小細胞性貧血、小細胞低色素性貧血。
診斷
紅細胞平均體積(MCV)、紅細胞平均血紅蛋白(MCH)、紅細胞平均血紅蛋白濃度(MCHC)的檢測值均低於正常值以下,即可診斷為“小細胞低色素性貧血”。即MCV<80fl,MCH<28pg,MCHC<32%。
小細胞低色素性貧血主要包括:
詳細分類
三種貧血
(1)缺鐵性貧血:是指各種原因使體內貯存鐵消耗怠盡,紅細胞的成熟受到影響的貧血。其特點是骨髓、肝、脾及其它組織中缺乏可染色鐵。血清鐵蛋白、血清鐵及轉鐵蛋白飽和度降低。
(2)珠蛋白生成障礙性貧血:主要是重型β地中海貧血、輕型β地中海貧血、HbH病。它們常有家族史、血片中可見多數靶形紅細胞,可見胎兒血紅蛋白(HbF)或血紅蛋白A2(HbA2)或HbH增高。患者的血清鐵、轉鐵蛋白飽和度、骨髓可染鐵均增多。
(3)鐵粒幼細胞貧血:包括多種原因引起的低色素性貧血。血紅素合成障礙和鐵利用不良,伴有紅細胞無效生成是此類貧血發生的共同機理。其血液學的共同特點為骨髓中鐵粒幼細胞顯著增多,其中很多細胞中的鐵小粒在核周圍排列成環狀,外周血中的紅細胞呈明顯的低色素特徵,血清鐵濃度顯著增高,單核—巨噬細胞中含鐵血黃素顯著增多。它可分為:
①遺傳性鐵粒幼細胞貧血:較為少見。這類貧血可能還包括幾種遺傳類型和治療效應不相同的貧血。
 小細胞低色素貧血
小細胞低色素貧血②獲得性鐵粒幼細胞貧血:它又分為原發性、藥物或毒物伴發、其它疾病伴發。原發性鐵粒幼細胞貧血亦稱難治性幼紅細胞貧血。這種貧血較為少見,在我國尤為罕見。有一些病例對吡哆醇治療有較好的效應。
三種症狀
(4)轉鐵蛋白缺乏症:亦稱無轉鐵蛋白血症,是指由於遺傳上的缺陷,在患者的血漿中缺少或缺乏轉鐵蛋白。肝、脾、胰腺中有大量鐵的貯積,而骨髓中無可利用的鐵以合成血紅蛋白。這種病非常罕見。
(5)原發性肺含鐵血黃素沉著症和肺腎出血綜合徵:原發性肺含鐵血黃素沉著症是一種罕見的鐵代謝異常疾病,其特點為廣泛的肺毛細血管出血,肺泡中有大量含鐵血黃素沉著,同時伴有缺鐵性貧血。主要的臨床表現為反覆發作的咯血、氣急和貧血。肺腎出血綜合徵亦稱Goodpasture綜合徵,也是一種罕見病。與原發性肺含鐵血黃素沉著症相似,其特點亦為肺泡中出血的反覆發作和缺鐵性貧血,但同時還有腎小球性腎炎病變和表現。
小細胞低色素貧血
小細胞低色素貧血(6)慢性感染性貧血和其它:慢性感染性貧血,血清鐵雖然降低,但總鐵結合力不會增加或降低,故轉鐵蛋白飽和度正常或稍增加。血清鐵蛋白常有增高。骨髓中鐵粒幼細胞數量減少,含鐵血黃素顆粒明顯增多。其它如鉛中毒可出現小細胞低色素性貧血。
預防和治療
(1)供給高蛋白飲食:
各種血細胞的增值分化和再生,都需要依賴蛋白質作為基礎,所以再障病人在飲食方面更需要供給營養價值高的動物性蛋白質,如含蛋白質豐富的瘦肉、蛋類、魚類、乳類、雞肉、豆製品及動物腎臟等。另外多吃鱉、龜、及動物骨或骨髓熬湯等。
(2)補充造血物質:
雖然再障不是由於缺乏造血物質取法所至,但是由於反覆出血,長可導致慢性失血性貧血,從而加重再障的貧血程度,因此食物中常應補充含鐵質和維生素豐富的食品,如枸杞子、赤小豆、黑芝麻、豬肝、黃鱔等,以及新鮮蔬菜如西紅柿、芹菜、菠菜、萵苣等,不僅可以改善貧血,而且可以預防出血。
(3)補鐵:
鐵是血紅蛋白的組成成分,血紅蛋白參與氧的運輸和存儲。由於體內鐵的儲存不能滿足正常紅細胞生成的需要而發生的貧血稱為缺鐵性貧血,一般會在持續缺鐵3~5個月時發生。 補充鐵劑,一定要與餐共食或餐後服用,可以降低鐵質對腸胃到的刺激性,同時食物中的蛋白質,更可以提高鐵質的吸收率,可服用含有乳酸亞鐵的補鐵製劑,如果能夠隨富含維生素C的水果或果汁服用,吸收率會更佳。
(4)飲食宜忌:
出血患者宜吃清淡和宜消化食物,忌油膩、辛辣刺激性食物;外感發熱患者宜多飲水;多吃蓮藕、西瓜或用梨皮、鮮茅根、鮮蘆根、荷葉等煎湯當茶飲。

